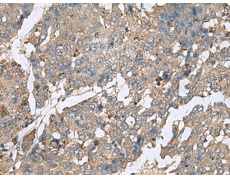
一抗

中文名稱: 兔抗PLA2G2A多克隆抗體
英文名稱: Anti-PLA2G2A rabbit polyclonal antibody
別 名: phospholipase A2 group IIA; MOM1; PLA2; PLA2B; PLA2L; PLA2S; PLAS1; sPLA2
相關(guān)類別: 一抗
儲 存: 冷凍(-20℃)
宿 主: Rabbit
抗 原: PLA2G2A
反應(yīng)種屬: Human
標 記 物: Unconjugate
克隆類型: rabbit polyclonal
技術(shù)規(guī)格
|
Background: |
The protein encoded by this gene is a member of the phospholipase A2 family (PLA2). PLA2s constitute a diverse family of enzymes with respect to sequence, function, localization, and divalent cation requirements. This gene product belongs to group II, which contains secreted form of PLA2, an extracellular enzyme that has a low molecular mass and requires calcium ions for catalysis. It catalyzes the hydrolysis of the sn-2 fatty acid acyl ester bond of phosphoglycerides, releasing free fatty acids and lysophospholipids, and thought to participate in the regulation of the phospholipid metabolism in biomembranes. Several alternatively spliced transcript variants with different 5' UTRs have been found for this gene. |
|
Applications: |
ELISA, IHC |
|
Name of antibody: |
PLA2G2A |
|
Immunogen: |
Fusion protein of human PLA2G2A |
|
Full name: |
phospholipase A2 group IIA |
|
Synonyms: |
MOM1; PLA2; PLA2B; PLA2L; PLA2S; PLAS1; sPLA2 |
|
SwissProt: |
P14555 |
|
ELISA Recommended dilution: |
5000-10000 |
|
IHC positive control: |
Human liver cancer |
|
IHC Recommend dilution: |
50-200 |

 購物車
購物車 幫助
幫助
 021-54845833/15800441009
021-54845833/15800441009